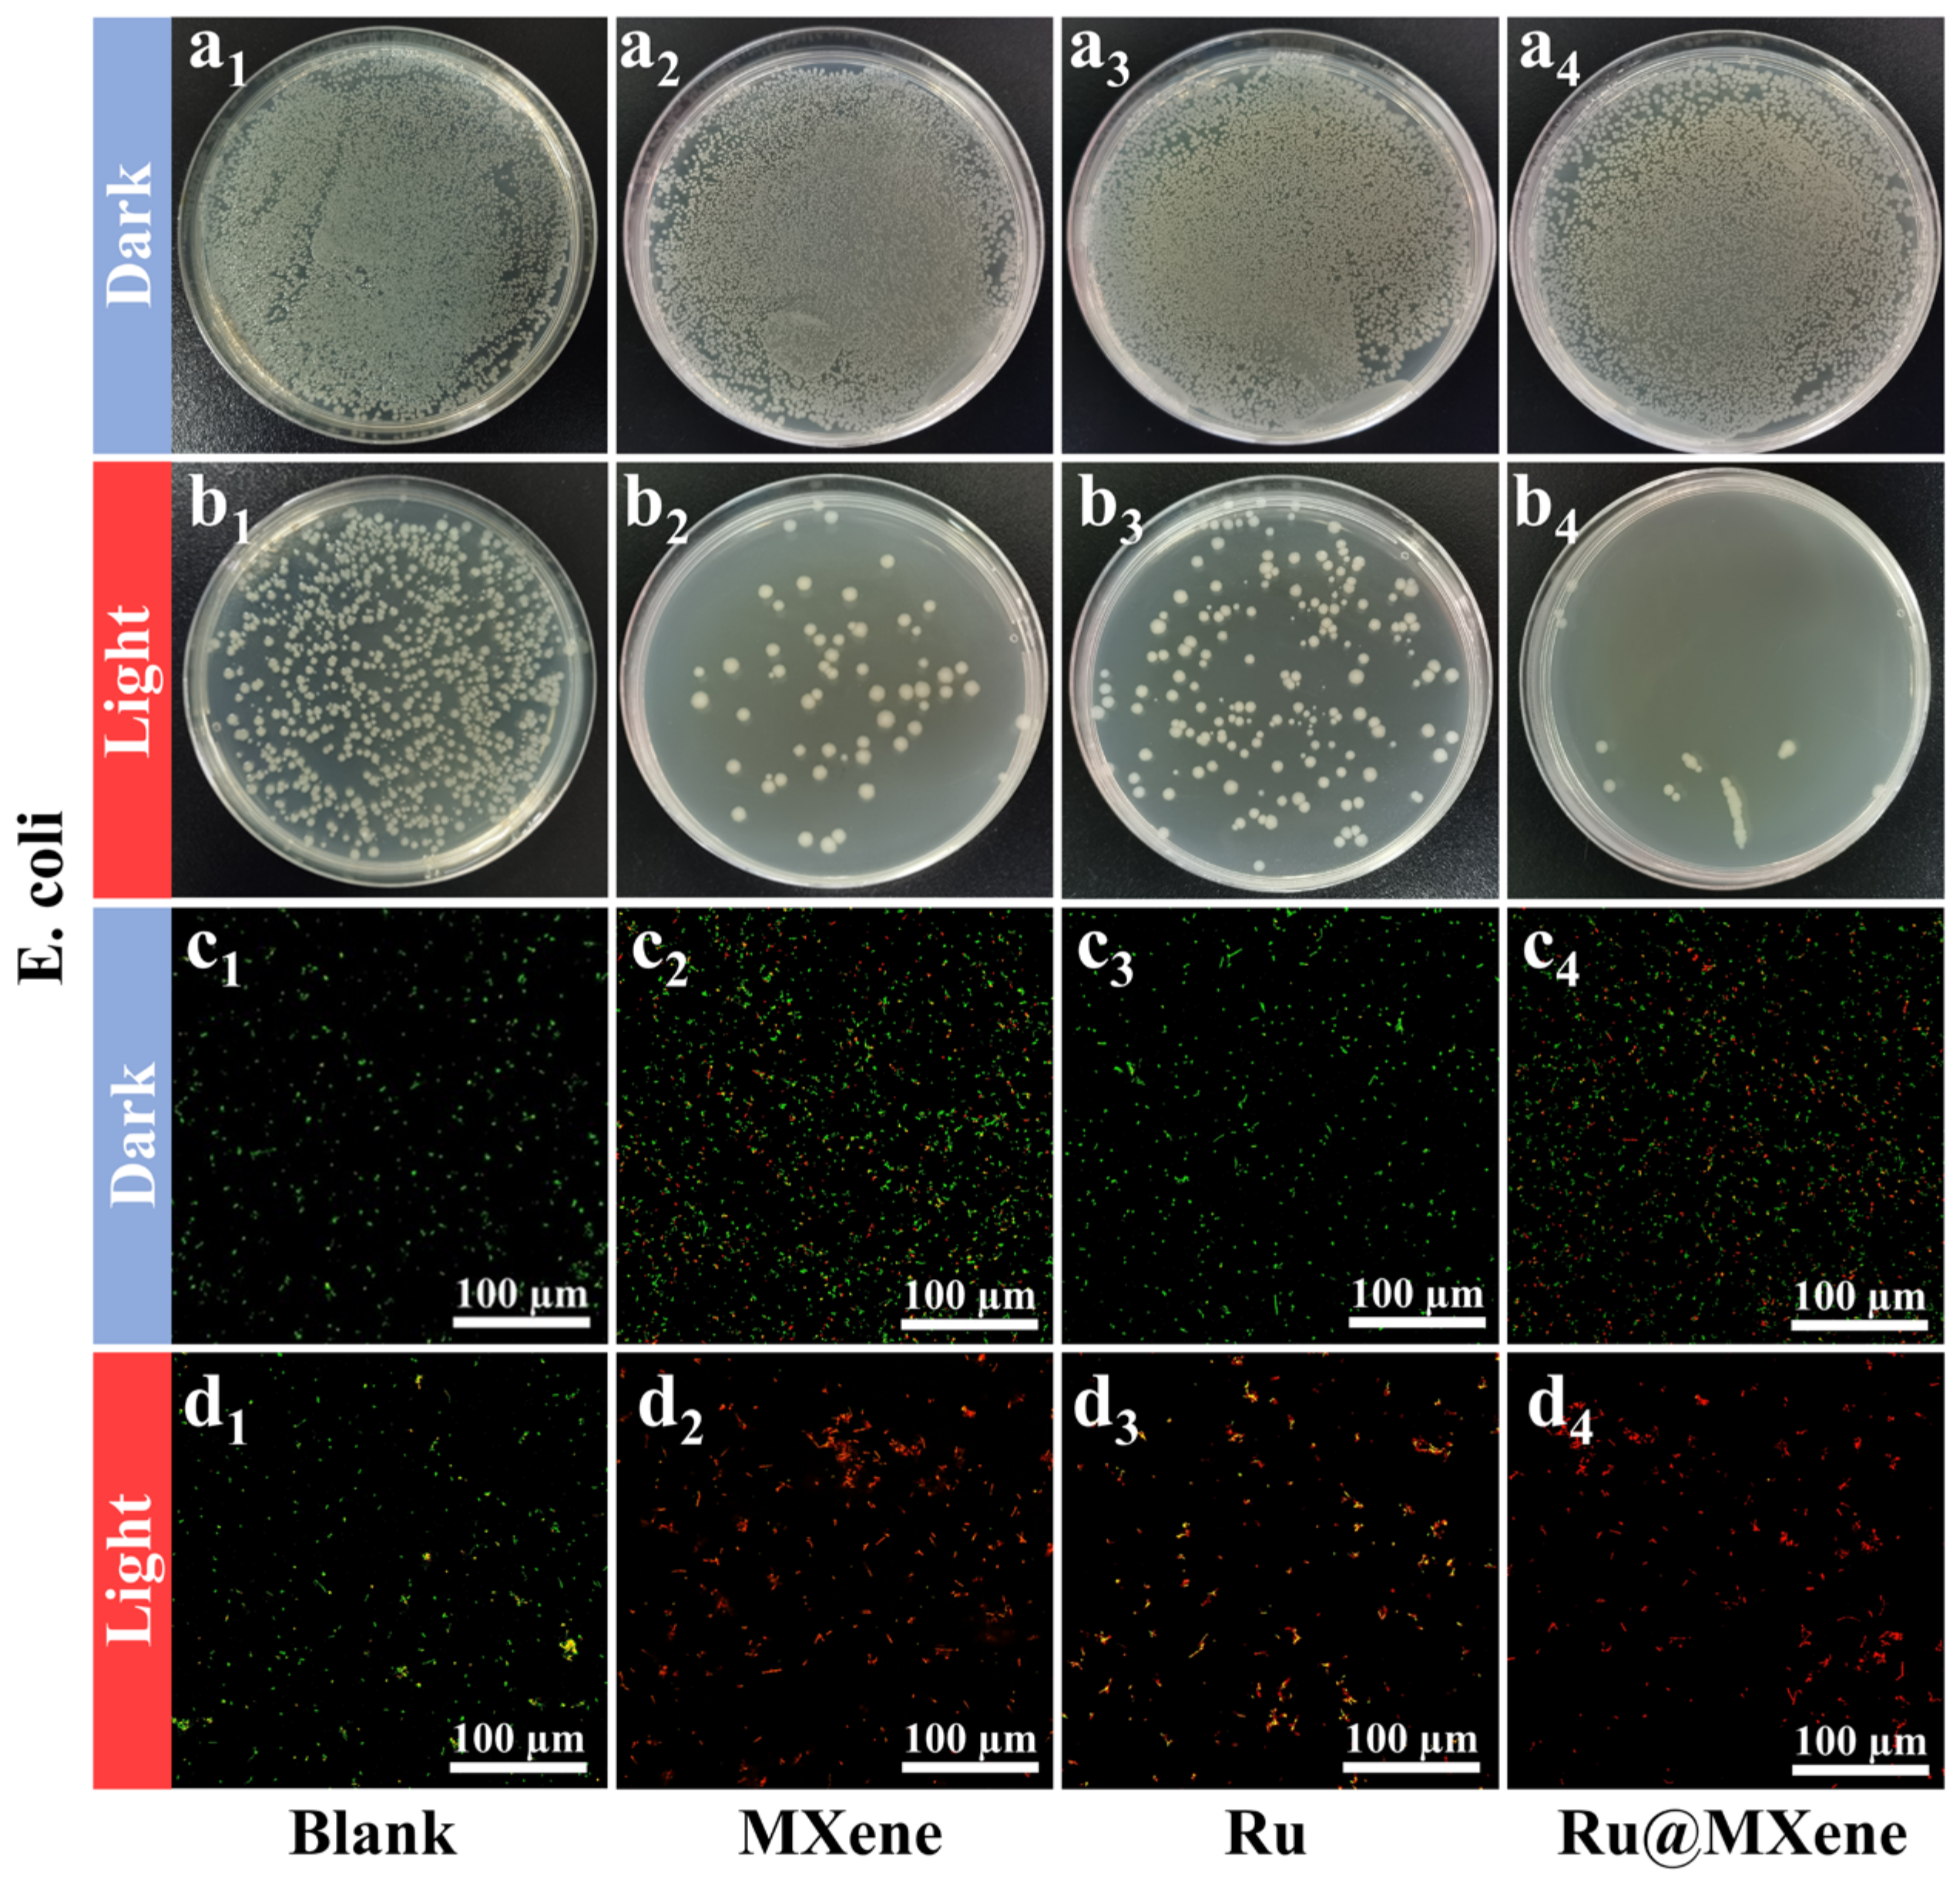
Nanomaterials 13 00958 g007 Nanomaterials 13 00958 g007
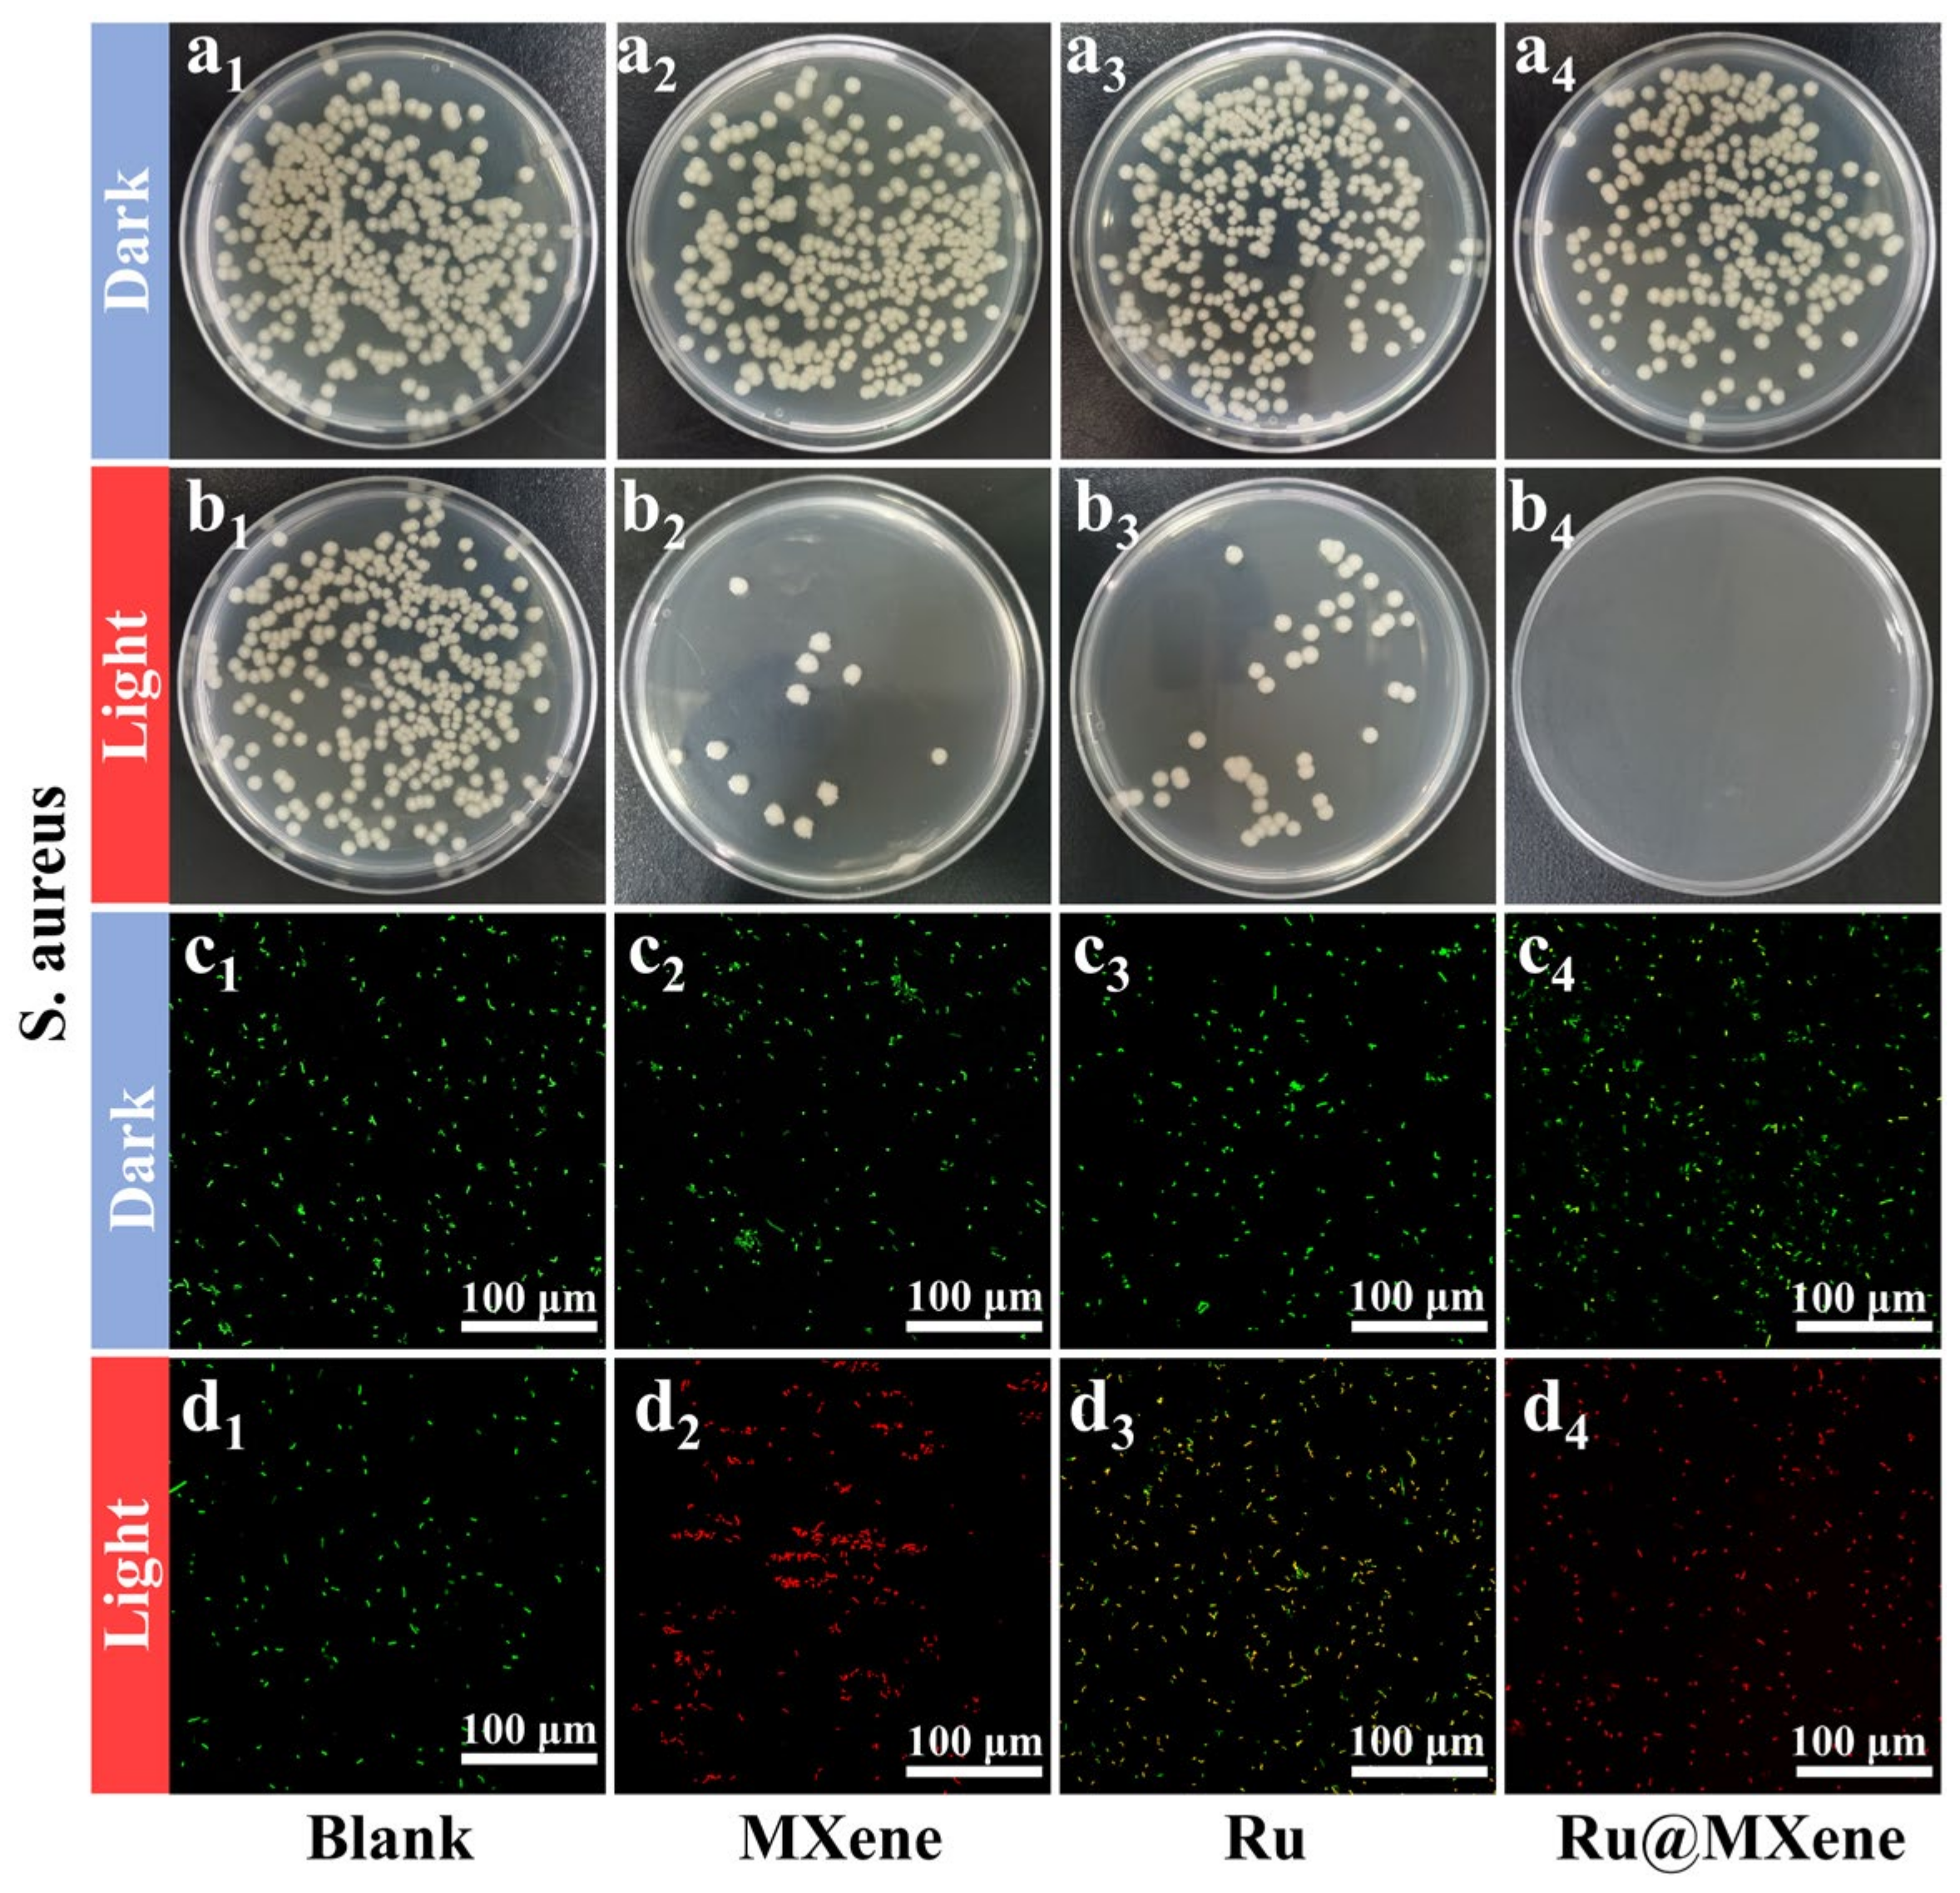
Nanomaterials 13 00958 g008 Nanomaterials 13 00958 g008

Ru(II) Complex Grafted Ti3C2Tx MXene Nano Sheet with Photothermal/Photodynamic Synergistic Antibacterial Activity
Abstract
1. Introduction
2. Experimental Methods
2.1. Materials
2.2. Characterization
2.3. Ti3C2Tx MXene Preparation
2.4. Synthesis of cis-[Ru(bpy)2Cl2]·2H2O
2.5. Synthesis of Ru(bpy)2(dcb)Cl2
2.6. Fabrication of Ru@MXene Nanocomposites
2.7. Load of Ru on Ru@MXene
2.8. Detection of ROS
2.9. Photothermal Experiments
2.10. Antibacterial Activity Assessments
2.11. Ellman’s Assay
3. Results and Discussions
3.1. Morphological Observations
3.2. Chemical Structure Analysis
3.3. Photodynamic Properties
3.4. Photothermal Properties
3.5. Photoinactivation of E. coli and S. aureus
3.6. Investigation of the Mechanism of Synergistic Antibacterial Effect
4. Conclusions
Supplementary Materials
Author Contributions
Funding
Data Availability Statement
Conflicts of Interest
References
- Zeshan, B.; Karobari, M.I.; Afzal, N.; Siddiq, A.; Basha, S.; Basheer, S.N.; Peeran, S.W.; Mustafa, M.; Daud, N.H.A.; Ahmed, N.; et al. The Usage of Antibiotics by COVID-19 Patients with Comorbidities: The Risk of Increased Antimicrobial Resistance. Antibiotics 2022, 11, 35. [Google Scholar] [CrossRef] [PubMed]
- Walsh, C. Molecular mechanisms that confer antibacterial drug resistance. Nature 2000, 406, 775–781. [Google Scholar] [CrossRef] [PubMed]
- Lam, S.J.; O’Brien-Simpson, N.M.; Pantarat, N.; Sulistio, A.; Wong, E.H.H.; Chen, Y.-Y.; Lenzo, J.C.; Holden, J.A.; Blencowe, A.; Reynolds, E.C.; et al. Combating multidrug-resistant Gram-negative bacteria with structurally nanoengineered antimicrobial peptide polymers. Nat. Microbiol. 2016, 1, 16162. [Google Scholar] [CrossRef] [PubMed]
- Kresse, H.; Belsey, M.J.; Rovini, H. The antibacterial drugs market. Nat. Rev. Drug Discov. 2007, 6, 19–20. [Google Scholar] [CrossRef]
- Boucher, H.W. Challenges in anti-infective development in the era of bad bugs, no drugs: A regulatory perspective using the example of bloodstream infection as an indication. Clin. Infect. Dis. 2010, 50, 4–9. [Google Scholar] [CrossRef]
- Zhu, X.; Zhu, Y.; Jia, K.; Abraha, B.S.; Li, Y.; Peng, W.; Zhang, F.; Fan, X.; Zhang, L. A near-infrared light-mediated antimicrobial based on Ag/Ti3C2Tx for effective synergetic antibacterial applications. Nanoscale 2020, 12, 19129–19141. [Google Scholar] [CrossRef] [PubMed]
- Knoblauch, R.; Harvey, A.; Ra, E.; Greenberg, K.M.; Lau, J.; Hawkins, E.; Geddes, C.D. Antimicrobial carbon nanodots: Photodynamic inactivation and dark antimicrobial effects on bacteria by brominated carbon nanodots. Nanoscale 2021, 13, 85–99. [Google Scholar] [CrossRef] [PubMed]
- Rosenkranz, A.; Perini, G.; Aguilar-Hurtado, J.Y.; Zambrano, D.F.; Wang, B.; Niccolini, B.; Henriques, P.C.; Rosa, E.; De Maio, F.; Delogu, G.; et al. Laser-Mediated antibacterial effects of Few- and Multi-Layer Ti3C2Tx MXenes. Appl. Surf. Sci. 2021, 567, 150795. [Google Scholar] [CrossRef]
- Zou, Y.; Zhang, Y.; Yu, Q.; Chen, H. Photothermal bactericidal surfaces: Killing bacteria using light instead of biocides. Biomater. Sci. 2021, 9, 10–22. [Google Scholar] [CrossRef]
- Wang, Y.Q.; Jin, Y.Y.; Chen, W.; Wang, J.J.; Chen, H.; Sun, L.; Li, X.; Ji, J.; Yu, Q.; Shen, L.Y.; et al. Construction of nanomaterials with targeting phototherapy properties to inhibit resistant bacteria and biofilm infections. Chem. Eng. J. 2019, 358, 74–90. [Google Scholar] [CrossRef]
- Ren, Y.; Liu, H.; Liu, X.; Zheng, Y.; Li, Z.; Li, C.; Yeung, K.W.K.; Zhu, S.; Liang, Y.; Cui, Z.; et al. Photoresponsive Materials for Antibacterial Applications. Cell Rep. Phys. Sci. 2020, 1, 100245. [Google Scholar] [CrossRef]
- Liu, G.; Zou, J.; Tang, Q.; Yang, X.; Zhang, Y.; Zhang, Q.; Huang, W.; Chen, P.; Shao, J.; Dong, X. Surface Modified Ti3C2 MXene Nanosheets for Tumor Targeting Photothermal/Photodynamic/Chemo Synergistic Therapy. ACS Appl. Mater. Interfaces 2017, 9, 40077–40086. [Google Scholar] [CrossRef]
- Kim, J.; Park, S.; Lee, J.E.; Jin, S.M.; Lee, J.H.; Lee, I.S.; Yang, I.; Kim, J.-S.; Kim, S.K.; Cho, M.-H.; et al. Designed Fabrication of Multifunctional Magnetic Gold Nanoshells and Their Application to Magnetic Resonance Imaging and Photothermal Therapy. Angew. Chem. 2006, 118, 7918–7922. [Google Scholar] [CrossRef]
- Hu, D.; Li, H.; Wang, B.; Ye, Z.; Lei, W.; Jia, F.; Jin, Q.; Ren, K.-F.; Ji, J. Surface-Adaptive Gold Nanoparticles with Effective Adherence and Enhanced Photothermal Ablation of Methicillin-Resistant Staphylococcus aureus Biofilm. ACS Nano 2017, 11, 9330–9339. [Google Scholar] [CrossRef] [PubMed]
- Ou, G.; Li, Z.; Li, D.; Cheng, L.; Liu, Z.; Wu, H. Photothermal therapy by using titanium oxide nanoparticles. Nano Res. 2016, 9, 1236–1243. [Google Scholar] [CrossRef]
- Yang, W.; Guo, W.; Le, W.; Lv, G.; Zhang, F.; Shi, L.; Wang, X.; Wang, J.; Wang, S.; Chang, J.; et al. Albumin-Bioinspired Gd:CuS Nanotheranostic Agent for In Vivo Photoacoustic/Magnetic Resonance Imaging-Guided Tumor-Targeted Photothermal Therapy. ACS Nano 2016, 10, 10245–10257. [Google Scholar] [CrossRef]
- Li, B.; Ye, K.; Zhang, Y.; Qin, J.; Zou, R.; Xu, K.; Huang, X.; Xiao, Z.; Zhang, W.; Lu, X.; et al. Photothermal Theragnosis Synergistic Therapy Based on Bimetal Sulphide Nanocrystals Rather Than Nanocomposites. Adv. Mater. 2015, 27, 1339–1345. [Google Scholar] [CrossRef] [PubMed]
- He, R.; Huang, X.; Chee, M.; Hao, F.; Dong, P. Carbon-based perovskite solar cells: From single-junction to modules. Carbon Energy 2019, 1, 109–123. [Google Scholar] [CrossRef]
- Yuan, Y.; Lu, J. Demanding energy from carbon. Carbon Energy 2019, 1, 8–12. [Google Scholar] [CrossRef]
- Weng, Y.; Guan, S.; Wang, L.; Lu, H.; Meng, X.; Waterhouse, G.I.N.; Zhou, S. Defective Porous Carbon Polyhedra Decorated with Copper Nanoparticles for Enhanced NIR-Driven Photothermal Cancer Therapy. Small 2020, 16, 1905184. [Google Scholar] [CrossRef] [PubMed]
- Lu, S.; Liu, F.; Qiu, P.; Qiao, M.; Li, Y.; Cheng, Z.; Xue, N.; Hou, X.; Xu, C.; Xiang, Y.; et al. Photothermal-assisted photocatalytic degradation with ultrahigh solar utilization: Towards practical application. Chem. Eng. J. 2020, 379, 122382. [Google Scholar] [CrossRef]
- Hui, L.; Auletta, J.T.; Huang, Z.; Chen, X.; Xia, F.; Yang, S.; Liu, H.; Yang, L. Surface Disinfection Enabled by a Layer-by-Layer Thin Film of Polyelectrolyte-Stabilized Reduced Graphene Oxide upon Solar Near-Infrared Irradiation. ACS Appl. Mater. Interfaces 2015, 7, 10511–10517. [Google Scholar] [CrossRef] [PubMed]
- Murakami, T.; Nakatsuji, H.; Inada, M.; Matoba, Y.; Umeyama, T.; Tsujimoto, M.; Isoda, S.; Hashida, M.; Imahori, H. Photodynamic and Photothermal Effects of Semiconducting and Metallic-Enriched Single-Walled Carbon Nanotubes. J. Am. Chem. Soc. 2012, 134, 17862–17865. [Google Scholar] [CrossRef] [PubMed]
- Makabenta, J.M.V.; Nabawy, A.; Li, C.H.; Schmidt-Malan, S.; Patel, R.; Rotello, V.M. Nanomaterial-based therapeutics for antibiotic-resistant bacterial infections. Nat. Rev. Microbiol. 2021, 19, 23–36. [Google Scholar] [CrossRef]
- Wang, C.; Xu, H.; Liang, C.; Liu, Y.; Li, Z.; Yang, G.; Cheng, L.; Li, Y.; Liu, Z. Iron Oxide @ Polypyrrole Nanoparticles as a Multifunctional Drug Carrier for Remotely Controlled Cancer Therapy with Synergistic Antitumor Effect. ACS Nano 2013, 7, 6782–6795. [Google Scholar] [CrossRef]
- Song, X.; Liang, C.; Gong, H.; Chen, Q.; Wang, C.; Liu, Z. Photosensitizer-Conjugated Albumin−Polypyrrole Nanoparticles for Imaging-Guided In Vivo Photodynamic/Photothermal Therapy. Small 2015, 11, 3932–3941. [Google Scholar] [CrossRef] [PubMed]
- Wang, W.-N.; Pei, P.; Chu, Z.-Y.; Chen, B.-J.; Qian, H.-S.; Zha, Z.-B.; Zhou, W.; Liu, T.; Shao, M.; Wang, H. Bi2S3 coated Au nanorods for enhanced photodynamic and photothermal antibacterial activities under NIR light. Chem. Eng. J. 2020, 397, 125488. [Google Scholar] [CrossRef]
- Kamysbayev, V.; Filatov, A.S.; Hu, H.; Rui, X.; Lagunas, F.; Wang, D.; Klie, R.F.; Talapin, D.V. Covalent surface modifications and superconductivity of two-dimensional metal carbide MXenes. Science 2020, 369, 979–983. [Google Scholar] [CrossRef]
- Huang, K.; Li, Z.; Lin, J.; Han, G.; Huang, P. Two-dimensional transition metal carbides and nitrides (MXenes) for biomedical applications. Chem. Soc. Rev. 2018, 47, 5109–5124. [Google Scholar] [CrossRef]
- Huang, H.; Jiang, R.; Feng, Y.; Ouyang, H.; Zhou, N.; Zhang, X.; Wei, Y. Recent development and prospects of surface modification and biomedical applications of MXenes. Nanoscale 2020, 12, 1325–1338. [Google Scholar] [CrossRef]
- Lin, H.; Wang, X.; Yu, L.; Chen, Y.; Shi, J. Two-Dimensional Ultrathin MXene Ceramic Nanosheets for Photothermal Conversion. Nano Lett. 2017, 17, 384–391. [Google Scholar] [CrossRef]
- Alimohammadi, F.; Sharifian, M.G.; Attanayake, N.H.; Thenuwara, A.C.; Gogotsi, Y.; Anasori, B.; Strongin, D.R. Antimicrobial Properties of 2D MnO2 and MoS2 Nanomaterials Vertically Aligned on Graphene Materials and Ti3C2 MXene. Langmuir 2018, 34, 7192–7200. [Google Scholar] [CrossRef]
- Liu, Y.; Tian, Y.; Han, Q.; Yin, J.; Zhang, J.; Yu, Y.; Yang, W.; Deng, Y. Synergism of 2D/1D MXene/cobalt nanowire heterojunctions for boosted photo-activated antibacterial application. Chem. Eng. J. 2021, 410, 128209. [Google Scholar] [CrossRef]
- Cheng, H.; Wang, J.; Yang, Y.; Shi, H.; Shi, J.; Jiao, X.; Han, P.; Yao, X.; Chen, W.; Wei, X.; et al. Ti3C2Tx MXene Modified with ZnTCPP with Bacteria Capturing Capability and Enhanced Visible Light Photocatalytic Antibacterial Activity. Small 2022, 18, 2200857. [Google Scholar] [CrossRef] [PubMed]
- Rademaker-Lakhai, J.M.; van den Bongard, D.; Pluim, D.; Beijnen, J.H.; Schellens, J.H.M. A Phase I and Pharmacological Study with Imidazolium-trans-DMSO-imidazole-tetrachlororuthenate, a Novel Ruthenium Anticancer Agent. Clin. Cancer Res. 2004, 10, 3717–3727. [Google Scholar] [CrossRef]
- Gill, M.R.; Thomas, J.A. Ruthenium(II) polypyridyl complexes and DNA--from structural probes to cellular imaging and therapeutics. Chem. Soc. Rev. 2012, 41, 3179–3192. [Google Scholar] [CrossRef]
- Li, F.; Collins, J.G.; Keene, F.R. Ruthenium complexes as antimicrobial agents. Chem. Soc. Rev. 2015, 44, 2529–2542. [Google Scholar] [CrossRef]
- Huang, N.; Chen, X.; Zhu, X.; Xu, M.; Liu, J. Ruthenium complexes/polypeptide self-assembled nanoparticles for identification of bacterial infection and targeted antibacterial research. Biomaterials 2017, 141, 296–313. [Google Scholar] [CrossRef] [PubMed]
- Smith, N.A.; Zhang, P.; Greenough, S.E.; Horbury, M.D.; Clarkson, G.J.; McFeely, D.; Habtemariam, A.; Salassa, L.; Stavros, V.G.; Dowson, C.G.; et al. Combatting AMR: Photoactivatable ruthenium(ii)-isoniazid complex exhibits rapid selective antimycobacterial activity. Chem. Sci. 2017, 8, 395–404. [Google Scholar] [CrossRef]
- Lam, P.L.; Lu, G.L.; Hon, K.M.; Lee, K.W.; Ho, C.L.; Wang, X.; Tang, J.C.; Lam, K.H.; Wong, R.S.; Kok, S.H.; et al. Development of ruthenium(II) complexes as topical antibiotics against methicillin resistant Staphylococcus aureus. Dalton Trans. 2014, 43, 3949–3957. [Google Scholar] [CrossRef]
- Liao, X.; Liu, L.; Tan, Y.; Jiang, G.; Fang, H.; Xiong, Y.; Duan, X.; Jiang, G.; Wang, J. Synthesis of ruthenium complexes functionalized with benzothiophene and their antibacterial activity against Staphylococcus aureus. Dalton Trans. 2021, 50, 5607–5616. [Google Scholar] [CrossRef]
- Srivastava, P.; Shukla, M.; Kaul, G.; Chopra, S.; Patra, A.K. Rationally designed curcumin based ruthenium(ii) antimicrobials effective against drug-resistant Staphylococcus aureus. Dalton Trans. 2019, 48, 11822–11828. [Google Scholar] [CrossRef] [PubMed]
- Villemin, E.; Ong, Y.C.; Thomas, C.M.; Gasser, G. Polymer encapsulation of ruthenium complexes for biological and medicinal applications. Nat. Rev. Chem. 2019, 3, 261–282. [Google Scholar] [CrossRef]
- Knoll, J.D.; Turro, C. Control and utilization of ruthenium and rhodium metal complex excited states for photoactivated cancer therapy. Coord. Chem. Rev. 2015, 282, 110–126. [Google Scholar] [CrossRef] [PubMed]
- Poynton, F.E.; Bright, S.A.; Blasco, S.; Williams, D.C.; Kelly, J.M.; Gunnlaugsson, T. The development of ruthenium(II) polypyridyl complexes and conjugates for: In vitro cellular and in vivo applications. Chem. Soc. Rev. 2017, 46, 7706–7756. [Google Scholar] [CrossRef]
- Huang, H.; Yu, B.; Zhang, P.; Huang, J.; Chen, Y.; Gasser, G.; Ji, L.; Chao, H. Highly Charged Ruthenium(II) Polypyridyl Complexes as Lysosome-Localized Photosensitizers for Two-Photon Photodynamic Therapy. Angew. Chem. Int. Ed. 2015, 54, 14049–14052. [Google Scholar] [CrossRef] [PubMed]
- Joshi, T.; Pierroz, V.; Mari, C.; Gemperle, L.; Ferrari, S.; Gasser, G. A Bis(dipyridophenazine)(2-(2-pyridyl)pyrimidine-4-carboxylic acid)ruthenium(II) Complex with Anticancer Action upon Photodeprotection. Angew. Chem. Int. Ed. 2014, 53, 2960–2963. [Google Scholar] [CrossRef]
- Karges, J.; Kuang, S.; Maschietto, F.; Blacque, O.; Ciofini, I.; Chao, H.; Gasser, G. Rationally designed ruthenium complexes for 1- and 2-photon photodynamic therapy. Nat. Commun. 2020, 11, 3262. [Google Scholar] [CrossRef]
- Alhabeb, M.; Maleski, K.; Anasori, B.; Lelyukh, P.; Clark, L.; Sin, S.; Gogotsi, Y. Guidelines for Synthesis and Processing of 2D Titanium Carbide (Ti3C2Tx MXene). Chem. Mater. 2017, 29, 7633–7644. [Google Scholar] [CrossRef]
- Guo, Q.; Zhang, X.; Zhao, F.; Song, Q.; Su, G.; Tan, Y.; Tao, Q.; Zhou, T.; Yu, Y.; Zhou, Z.; et al. Protein-Inspired Self-Healable Ti3C2 MXenes/Rubber-Based Supramolecular Elastomer for Intelligent Sensing. ACS Nano 2020, 14, 2788–2797. [Google Scholar] [CrossRef]
- Xiao, F.; Liu, X.; Xiao, Y.; Chen, F.; Wu, Y. A luminescent layered hybrid Ag–Ru/LDH as a photocatalytic antibacterial agent. New J. Chem. 2017, 41, 7260–7266. [Google Scholar] [CrossRef]
- Yin, C.; Wang, Z.; Ding, X.; Chen, X.; Wang, J.; Yang, E.; Wang, W.; Martin, L.L.; Sun, D. Crystalline ruthenium polypyridine nanoparticles: A targeted treatment of bacterial infection with multifunctional antibacterial, adhesion and surface-anchoring photosensitizer properties. J. Mater. Chem. B 2021, 9, 3808–3825. [Google Scholar] [CrossRef] [PubMed]
- Lipatov, A.; Alhabeb, M.; Lukatskaya, M.R.; Boson, A.; Gogotsi, Y.; Sinitskii, A. Effect of synthesis on quality, electronic properties and environmental stability of individual monolayer Ti3C2 MXene flakes. Adv. Electron. Mater. 2016, 2, 1600255. [Google Scholar] [CrossRef]
- Boota, M.; Anasori, B.; Voigt, C.; Zhao, M.Q.; Barsoum, M.W.; Gogotsi, Y. Pseudocapacitive Electrodes Produced by Oxidant-Free Polymerization of Pyrrole between the Layers of 2D Titanium Carbide (MXene). Adv. Mater. 2016, 28, 1517–1522. [Google Scholar] [CrossRef] [PubMed]
- Xue, Q.; Zhang, H.; Zhu, M.; Pei, Z.; Li, H.; Wang, Z.; Huang, Y.; Huang, Y.; Deng, Q.; Zhou, J.; et al. Photoluminescent Ti3C2 MXene Quantum Dots for Multicolor Cellular Imaging. Adv. Mater. 2017, 29, 1604847. [Google Scholar] [CrossRef]
- Ahmed, B.; Anjum, D.H.; Hedhili, M.N.; Gogotsi, Y.; Alshareef, H.N. H2O2 assisted room temperature oxidation of Ti2C MXene for Li-ion battery anodes. Nanoscale 2016, 8, 7580–7587. [Google Scholar] [CrossRef] [PubMed]
- Ng, K.K.; Zheng, G. Molecular Interactions in Organic Nanoparticles for Phototheranostic Applications. Chem. Rev. 2015, 115, 11012–11042. [Google Scholar] [CrossRef]
- Lismont, M.; Dreesen, L.; Wuttke, S. Metal-Organic Framework Nanoparticles in Photodynamic Therapy: Current Status and Perspectives. Adv. Funct. Mater. 2017, 27, 1606314. [Google Scholar] [CrossRef]
- DeRosa, M.C.; Crutchley, R.J. Photosensitized singlet oxygen and its applications. Coordin. Chem. Rev. 2002, 233, 351–371. [Google Scholar] [CrossRef]
- Yan, B.; Zhou, M.; Liao, X.; Wang, P.; Yu, Y.; Yuan, J.; Wang, Q. Developing a Multifunctional Silk Fabric with Dual-Driven Heating and Rapid Photothermal Antibacterial Abilities Using High-Yield MXene Dispersions. ACS Appl. Mater. Interfaces 2021, 13, 43414–43425. [Google Scholar] [CrossRef]
- Xu, D.; Li, Z.; Li, L.; Wang, J. Insights into the Photothermal Conversion of 2D MXene Nanomaterials: Synthesis, Mechanism, and Applications. Adv. Funct. Mater. 2020, 30, 2000712. [Google Scholar] [CrossRef]
- Rasool, K.; Helal, M.; Ali, A.; Ren, C.E.; Gogotsi, Y.; Mahmoud, K.A. Antibacterial Activity of Ti3C2Tx MXene. ACS Nano 2016, 10, 3674–3684. [Google Scholar] [CrossRef] [PubMed]
- Chen, W.-H.; Luo, G.-F.; Lei, Q.; Hong, S.; Qiu, W.-X.; Liu, L.-H.; Cheng, S.-X.; Zhang, X.-Z. Overcoming the Heat Endurance of Tumor Cells by Interfering with the Anaerobic Glycolysis Metabolism for Improved Photothermal Therapy. ACS Nano 2017, 11, 1419–1431. [Google Scholar] [CrossRef] [PubMed]
- El-Tahawy, A.T.A. The crisis of antibiotic-resistance in bacteria. Saudi Med. J. 2004, 25, 837–842. [Google Scholar] [PubMed]
- Zhang, S.; Ye, J.; Liu, X.; Wang, Y.; Li, C.; Fang, J.; Chang, B.; Qi, Y.; Li, Y.; Ning, G. Titanium carbide/zeolite imidazole framework-8/polylactic acid electrospun membrane for near-infrared regulated photothermal/photodynamic therapy of drug-resistant bacterial infections. J. Colloid Interface Sci. 2021, 599, 390–403. [Google Scholar] [CrossRef]
- Wang, L.; Gao, F.; Wang, A.; Chen, X.; Li, H.; Zhang, X.; Zheng, H.; Ji, R.; Li, B.; Yu, X.; et al. Defect-Rich Adhesive Molybdenum Disulfide/rGO Vertical Heterostructures with Enhanced Nanozyme Activity for Smart Bacterial Killing Application. Adv. Mater. 2020, 32, 2005423. [Google Scholar] [CrossRef]
- Liu, W.; Cheng, W.; Zhou, M.; Xu, B.; Wang, P.; Wang, Q.; Yu, Y. Construction of multifunctional UV-resistant, antibacterial and photothermal cotton fabric via silver/melanin-like nanoparticles. Cellulose 2022, 29, 7477–7494. [Google Scholar] [CrossRef]
- Cheng, C.; Zhong, H.; Zhang, Y.; Gao, X.; Wang, J.; Liu, J.; Han, X. Bacterial responsive hydrogels based on quaternized chitosan and GQDs-epsilon-PL for chemo-photothermal synergistic anti-infection in diabetic wounds. Int. J. Biol. Macromol. 2022, 210, 377–393. [Google Scholar] [CrossRef]
- Fang, Y.; Pei, S.; Zhuo, L.; Cheng, P.; Yuan, H.; Zhang, L. Phosphorus and sulfur codoped carbon nitride nanosheets with enhanced photocatalytic antibacterial activity and promotion of wound healing. Appl. Surf. Sci. 2022, 586, 152761. [Google Scholar] [CrossRef]
- Shen, H.; Jiang, C.; Li, W.; Wei, Q.; Ghiladi, R.A.; Wang, Q. Synergistic Photodynamic and Photothermal Antibacterial Activity of In Situ Grown Bacterial Cellulose/MoS2-Chitosan Nanocomposite Materials with Visible Light Illumination. ACS Appl. Mater. Interfaces 2021, 13, 31193–31205. [Google Scholar] [CrossRef]
- Memar, M.Y.; Ghotaslou, R.; Samiei, M.; Adibkia, K. Antimicrobial use of reactive oxygen therapy: Current insights. Infect. Drug Resist. 2018, 11, 567–576. [Google Scholar] [CrossRef] [PubMed]

Disclaimer/Publisher’s Note: The statements, opinions and data contained in all publications are solely those of the individual author(s) and contributor(s) and not of MDPI and/or the editor(s). MDPI and/or the editor(s) disclaim responsibility for any injury to people or property resulting from any ideas, methods, instructions or products referred to in the content. |
© 2023 by the authors. Licensee MDPI, Basel, Switzerland. This article is an open access article distributed under the terms and conditions of the Creative Commons Attribution (CC BY) license (https://creativecommons.org/licenses/by/4.0/).
Share and Cite
Liu, X.; Xie, H.; Zhuo, S.; Zhou, Y.; Selim, M.S.; Chen, X.; Hao, Z. Ru(II) Complex Grafted Ti3C2Tx MXene Nano Sheet with Photothermal/Photodynamic Synergistic Antibacterial Activity. Nanomaterials 2023, 13, 958. https://doi.org/10.3390/nano13060958
Liu X, Xie H, Zhuo S, Zhou Y, Selim MS, Chen X, Hao Z. Ru(II) Complex Grafted Ti3C2Tx MXene Nano Sheet with Photothermal/Photodynamic Synergistic Antibacterial Activity. Nanomaterials. 2023; 13(6):958. https://doi.org/10.3390/nano13060958
Chicago/Turabian StyleLiu, Xiaofang, Hongchi Xie, Shi Zhuo, Yuanhong Zhou, Mohamed S. Selim, Xiang Chen, and Zhifeng Hao. 2023. "Ru(II) Complex Grafted Ti3C2Tx MXene Nano Sheet with Photothermal/Photodynamic Synergistic Antibacterial Activity" Nanomaterials 13, no. 6: 958. https://doi.org/10.3390/nano13060958
APA StyleLiu, X., Xie, H., Zhuo, S., Zhou, Y., Selim, M. S., Chen, X., & Hao, Z. (2023). Ru(II) Complex Grafted Ti3C2Tx MXene Nano Sheet with Photothermal/Photodynamic Synergistic Antibacterial Activity. Nanomaterials, 13(6), 958. https://doi.org/10.3390/nano13060958

